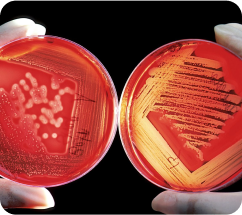
icon

Every module is carefully designed with verified material, the website on computers and the app on mobile devices are your true companions. You will have an enriching learning experience for you to confidently step ahead and succeed in your academic endeavours.

Elevate your medical career with targeted PG Medical Entrance prep and expert mock tests..

KriMay is dedicated to enhancing your preparation for competitive exams by providing a wide range of expertly crafted learning tools and resources. Our platform offers global study materials, personalized learning paths, in practice test environment, and with features such as progress tracking, performance analytics, and feedback mechanism, we ensure that you have everything you need to succeed. Join hands with us In your journey, and discover how KriMay can be your reliable partner in achieving your academic goals.
2500+ Students
Biochemistry

Anatomy

Physiology

Pharmacology

Microbiology

Pathology

Forensic Medicine

ENT

Ophthalmology

General Medicine

General Surgery
Obstetrics &
Gynecology
Choose the best plan that perfectly matches your goals and aspirations.
Each Subject
180 days unlimited practice
All prices are inclusive of GST. What you see is what you pay. Nothing more.
13 Subjects
730 days unlimited practice
₹9100
All prices are inclusive of GST. What you see is what you pay. Nothing more.
6 Subjects
365 days unlimited practice
₹4200
All prices are inclusive of GST. What you see is what you pay. Nothing more.